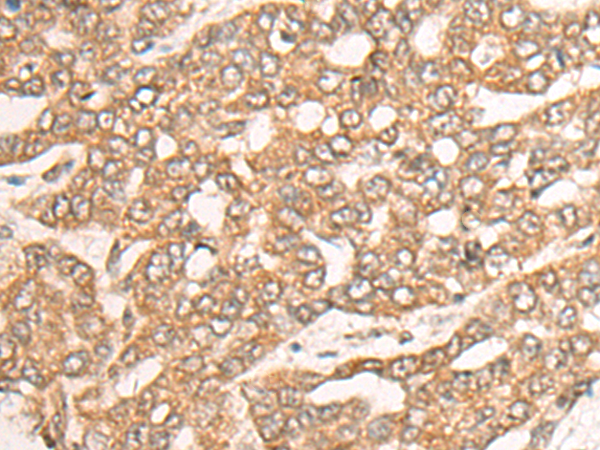
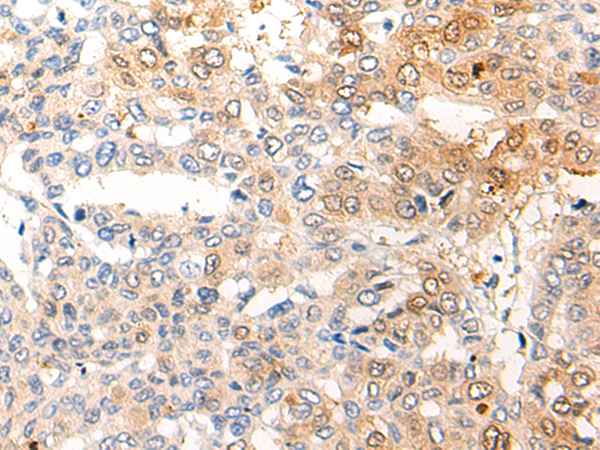
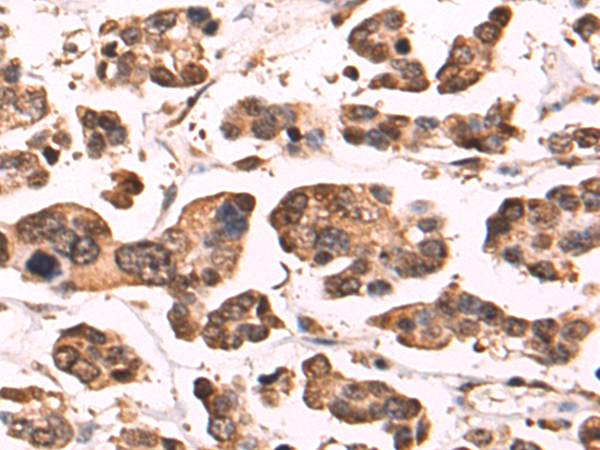
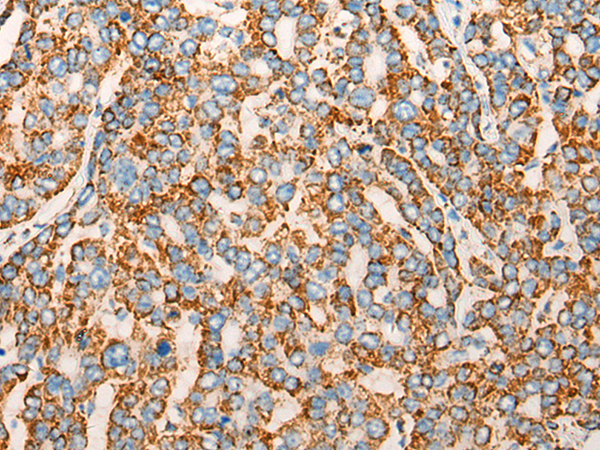

-
分类: 科研抗体货号: P09478别名: CENTA2; cent-b; HSA272195应用: IHC反应种属: Human, Mouse, Rat
-
分类: 科研抗体货号: P09480别名: CALT; CEN2应用: IHC反应种属: Human, Mouse
-
分类: 科研抗体货号: P09476别名: PAN; ADGF; CECR1; IDGFL; SNEDS; VAIHS应用: IHC反应种属: Human
-
分类: 科研抗体货号: P09497别名: SRA1; DAN16; SCAF6应用: IHC反应种属: Human
-
分类: 科研抗体货号: P09475别名: PCCP1应用: IHC反应种属: Human, Mouse
-
分类: 科研抗体货号: P09495别名: MIC14; C2orf9应用: WB,IHC反应种属: Human, Mouse
-
分类: 科研抗体货号: P09474别名: CDT2; RAMP; DCAF2; L2DTL应用: IHC反应种属: Human, Mouse
-
分类: 科研抗体货号: P09494别名: Mic19; MINOS3; PPP1R22应用: WB,IHC反应种属: Human, Mouse
-
分类: 科研抗体货号: P09473别名: CDO; CDON1; HPE11; ORCAM应用: IHC反应种属: Human
-
分类: 科研抗体货号: P09493别名:应用: IHC反应种属: Human, Mouse, Rat

鄂公网安备42018502007531号
鄂公网安备42018502007531号

